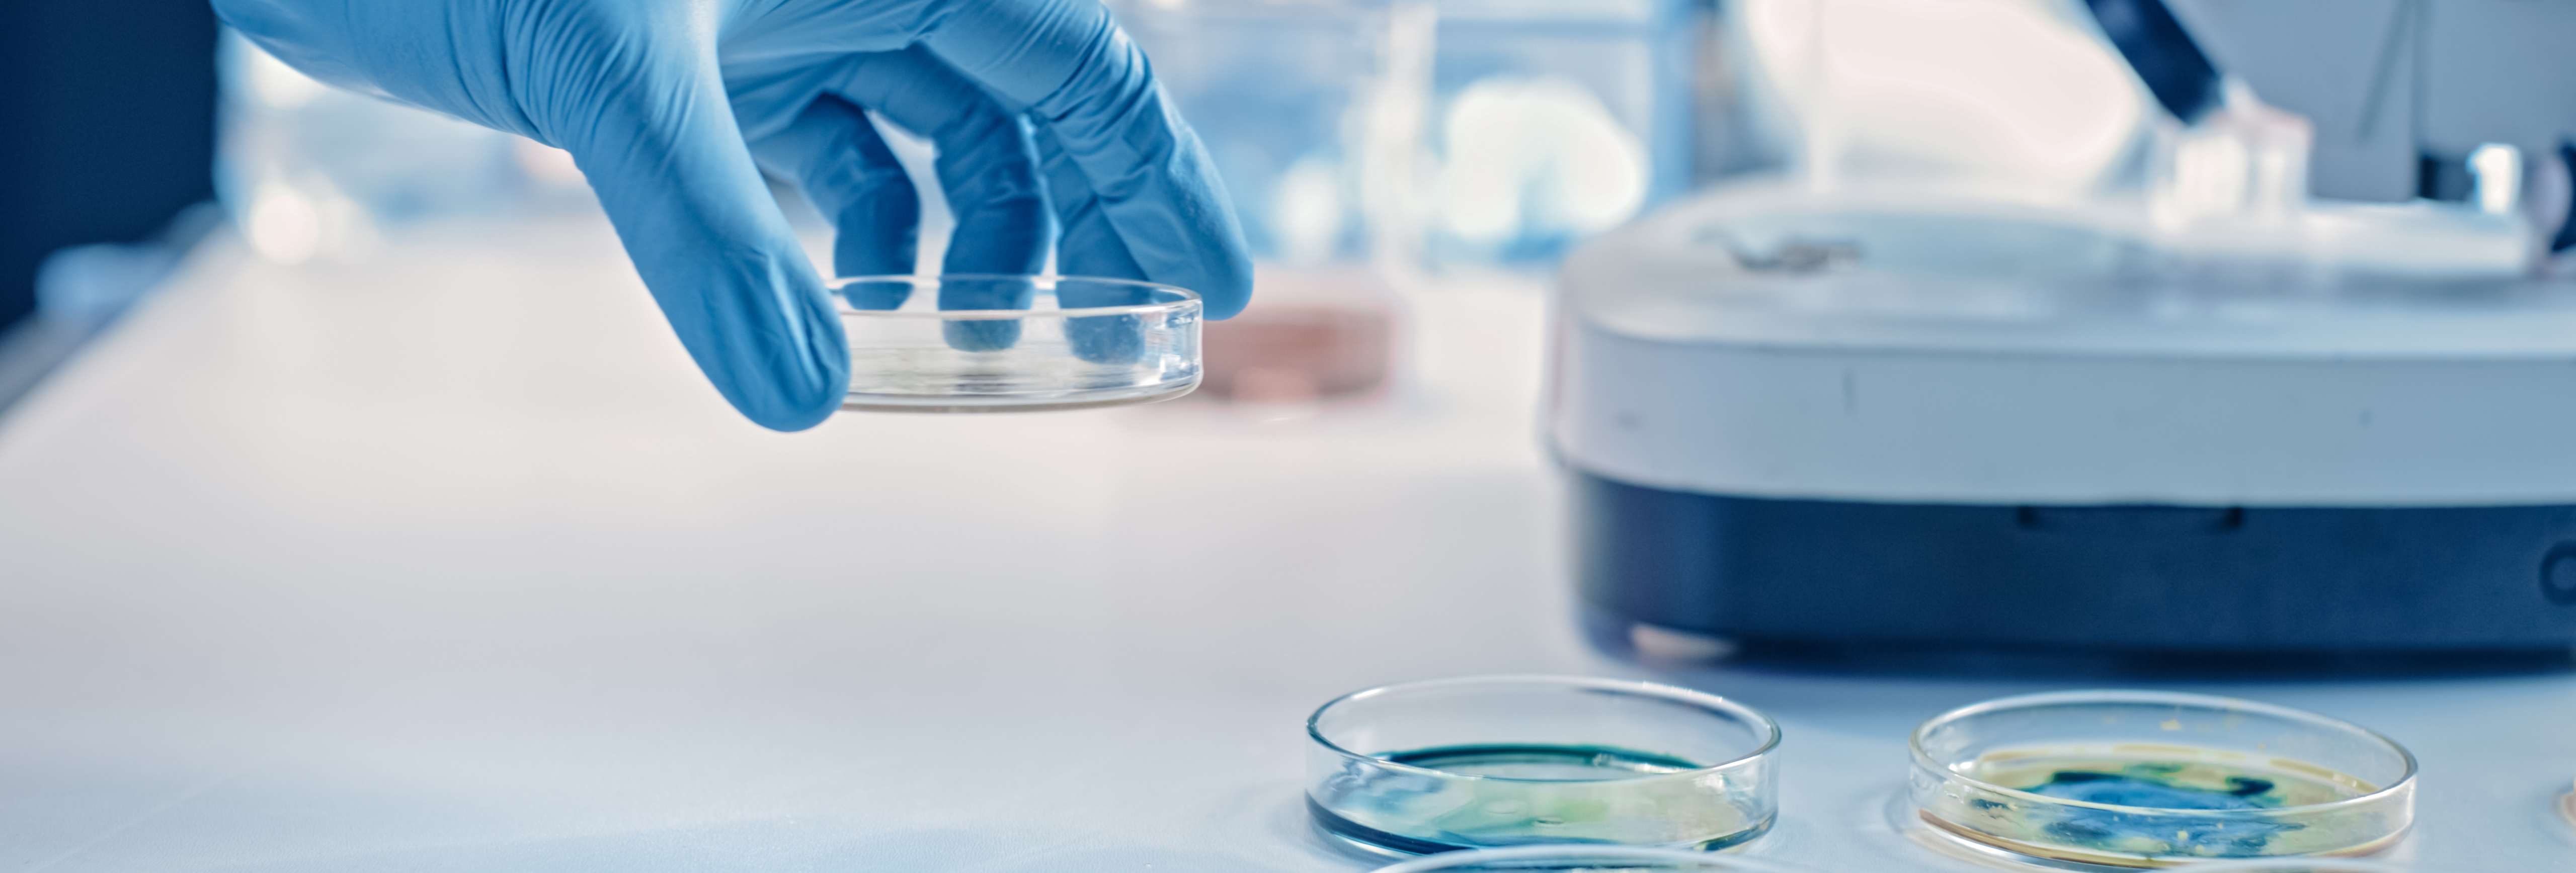

Préleveur auditeur qualité alimentaire H/F
Pour un de nos clients, acteur dans le secteur de la prévention des risques sanitaires liés à l'alimentation , nous recherchons un Préleveur auditeur qualité agroalimentaire.
Rôle & Mission
Rattaché(e) au responsable de secteur, vos missions sont:
- Piloter la préparation des audits avec les acteurs concernés et la documentation associée
- Prélèvements d'échantillons alimentaire, eaux surfaces pour les analyses à mettre en œuvre
- Gestion des envois d'échantillons vers les laboratoires
- Participer à la gestion des non-conformités, anomalies et réclamations
- Effectuer la gestion du planning des tournées
- Suivre les procédures en vigueur en fonction de l'activité du client audité
- Accompagner les clients sur la gestion de leurs problématiques en matière d'hygiène et qualité
- Conseiller les clients concernant leurs problématiques terrains
Le candidat idéal pour ce poste
Est titulaire d'un Bac+2 en agroalimentaire, biologie ou biochimie
Justifie d'une première expérience dans le domaine agroalimentaire
Est titulaire du permis B
Vous êtes dynamique, rigoureux et polyvalent.
Vous aimez le contact humain et travaillé en équipe, ce poste est fait pour vous !
Résumé du poste
Localisation
Grenoble (38)
Choisie pour vous


Auditeur Qualité Agroalimentaire
Paris (75)

CDD

9 mois

18 à 19K€


Assistant Qualité
Colombes (92)

Intérim

3 mois

25 à 30K€


Assistant commercial ADV
MAUGUIO (34)

CDI

25 à 28K€


ASSISTANT CONSEILLER CLIENT
CERGY (95)

Intérim

3 mois

20 à 21K€

Agent de transit AOG
Roissy - 95 (95)

CDD

6 mois

24 à 26K€


Assistant administratif et commercial
Goussainville (95)

Intérim

1 mois

19 à 20K€
 Retour à la liste
Retour à la liste




